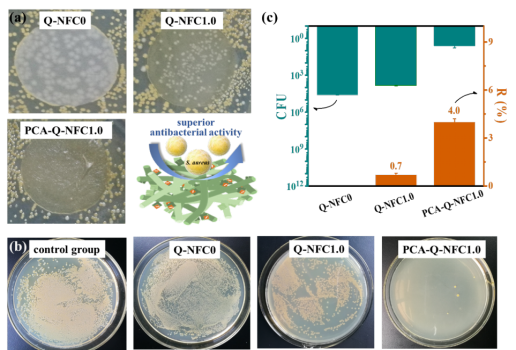

纳纤化纤维素(NFC)或纤维素纳米纤维(CNF)是一类主要从植物纤维素中拆解分离得到的、呈现高长径比纳米纤维(直径:2~100nm)无规缠绕网状形态的纳米纤维素。NFC不仅具有纤维素原有的特性,而且还兼具纳米纤维材料的特殊功能,如原料来源丰富、长径比大、轻质高强(重量仅为钢的1/5,强度则是钢材的5倍以上)、流变性能好、阻氧性高、生物降解性和生物安全性佳等优点,在复合材料、造纸、食品包装、日化用品、医用材料、环境修复等领域具有广阔的应用前景,被誉为未来最具潜力的新材料之一。
刘宏治教授领衔的“生物质高分子材料团队”在宁波市创新团队项目、省自然基金、广西壮族自治区重点研发计划等课题支持下,积极开展学科交叉、协同创新,近期在NFC功能化改性领域取得如下系列进展:
一、兼具紫外屏蔽和细胞相容性的非溶出型抗菌涂层

具有抗菌性能和生物相容性的NFC材料在食品保鲜、医用及化妆品等领域极具应用潜力。与直接添加无机(如纳米银和TiO2)或有机抗菌剂(如抗生素)方法相比,纤维表面预处理时接枝季铵盐基团的策略具有抗菌剂不易流失、膜透明性影响小且无耐药性等优点。NFC抗菌活性高低与其表面接枝的季铵盐基团含量(即取代度)密切相关,然而由于季铵化预处理的副反应和非均相反应限制,Q-NFC很难取得满意的取代度,而且过高的季铵盐基团引入会带来细胞毒性的弊端。
针对以上突出问题,刘宏治团队在季铵盐预处理过程中,将具有抗菌和抗氧化活性的4-香豆酸(PCA)通过简便的“阴离子交换”策略锚定在Q-NFC纤维表面。结果显示,通过非共价键引入源自天然资源的PCA阴离子后,不仅赋予了Q-NFC优异的紫外屏蔽功能和非溶出型抑菌效果,而且改性薄膜对金黄色葡萄球菌的抑菌率显著提升,并显示出更佳的体外细胞存活率和阻氧性能。此外,其它天然酚酸也被尝试,证明了该功能化改性策略的普适性。目前,该多功能化Q-NFC材料在食品保鲜和医用材料领域的应用正在进行。以上成果发表在ACS Sustainable Chemistry & Engineering2021, 9, 15755(IF=8.198,JCR二区)上。论文的第一作者为浙江农林大学硕士生茹静和浙大宁波理工学院王章慧讲师,通讯作者为浙大宁波理工学院刘宏治教授和宁波李惠利医疗中心彭兆祥主任医师。

二、无矿物添加的高效、透明阻燃抑烟涂层
NFC本身的易燃性为其在隔热、储能及包装等相关领域应用埋下安全隐患。目前,提高NFC阻燃性能的主要策略包括:添加以黏土为代表的无机填料、添加/接枝含阻燃元素(如磷和硼)的助剂或基团以及以上两种策略的协同。虽然部分研究已取得较为理想的阻燃效果,但仍存在矿物填料添加量高、复合纳米纸透光性差、燃烧中有毒烟气释放量大等弊端亟待解决。


针对以上突出问题,团队分别以漂白硫酸盐竹浆和未漂白高得率竹浆为原料,利用木质素组分作为成碳剂,通过化学预处理在纤维素表面引入季铵盐基团,机械分离出高度纳纤化的低木质素含量(<1wt%)的Q-NFC和高木质素含量(19wt%)的L-Q-NFC,然后经硼化改性策略制备出兼具阻燃抑烟功能的B/Q-NFC和L-B/Q-NFC材料。后硼化改性的NFC薄膜很好地保留NFC膜原有的透光性,而木质素组分存在虽然降低了NFC膜的透光性,但赋予其紫外屏蔽功能。

此外,硼化改性的NFC膜表现出良好成碳能力,B/Q-NFC和L-B/Q-NFC膜的成碳量分别达到37wt%和42wt%。锥形量热仪结果发现,接枝硼元素与木质素组分产生了高效协同阻燃抑烟效果,其热释放速率和总热释放速率分别较L-Q-NFC降低了80%和60%,释放的有毒烟雾减少了近99%。机理分析认为,燃烧初期涂覆的NFC阻燃层可以有效阻碍氧气以及热量从外部向基底的扩散。由于优异的成碳性能,基底表面随即被致密有序碳层覆盖,从而进一步阻止内部基底因高温所产生可燃气体的外逸。
以上成果发表在Chemical Engineering Journal2021, 419,129440(IF=13.273,JCR一区)上。论文第一作者为浙江农林大学硕士生童聪聪和浙大宁波理工学院张帅讲师,通讯作者为刘宏治教授,阻燃机理方面得到了方征平院长的指导。
三、高通量、高选择性的抗污聚酰胺纳滤膜
膜分离作为一种节能高效的新型分离技术,广泛应用于污水处理、海水淡化等领域。然而,现有聚酰胺(PA)纳滤膜主要存在着渗透性-选择性trade-off效应以及膜易污染的突出问题。为此,团队将磷酸酯化改性的P-CNF原位引入至PA基质中,制备出高性能的薄层纳米复合(TFN)纳滤膜。研究表明,引入P-CNF后,纳滤膜纯水渗透通量和Na2SO4截留率均得以提升,突破了渗透性-选择性之间的“trade-off”效应。得益于高Na2SO4截留率和低NaCl截留率,该纳滤膜表现出高达18.0的分离系数,远高于目前文献中报道的TFN纳滤膜。以上成果发表在Journal of Membrane Science2022,647,120339(IF=8.742,JCR一区)上。论文的第一作者和通讯作者为王章慧讲师,通讯作者为刘宏治教授和浙江大学朱利平教授。

为了同时解决渗透率-选择性相互制约和PA膜易污染的问题,团队进一步提出CNF和两性离子协同调控膜结构的新思路。首先,基于“两步预处理改性法”合成了表面接枝磷酸酯和季铵盐基团的两性离子CNF(Z-CNF),然后通过界面聚合法将其原位引入至PA基质内。引入Z-CNF后,纳滤膜的纯水渗透通量和Na2SO4截留率分别高达14.4 L m-2h-1bar-1和98.3%,实现了纳滤膜的渗透性和选择性的同步提升。在相同纳米材料添加量下(0.05%),Z-CNF@TFN膜的渗透选择性明显优于Q-CNF@TFN膜和P-CNF@TFN膜,表明超亲水两性基团引入有效提高了PA膜的渗透选择性。此外,使用BSA对膜进行污染,发现相比于PA膜,Z-CNF@TFN膜对于负电BSA和正电BSA均表现出较低的通量下降率和高的通量恢复率,显示优异的抗污性能。以上成果发表在Desalination2022,521,115397(IF=9.501, JCR一区)上。论文的第一作者为团队本科生夏道伟,通讯作者为王章慧讲师、刘宏治教授及浙江大学朱利平教授。

四、气凝胶型环境修复材料
磷是一种导致水体富营养化等现象的重要污染物。已有研究发现,镧(氢)氧化物对磷具有优异的亲和力,在高效脱磷领域拥有巨大潜力。但是,它们的粉末或颗粒在水中易发生团聚,导致吸附容量受限,且回收再生困难。此外,这类吸附剂孔径多为微孔和介孔,磷酸根离子难以扩散到吸附剂内部且扩散速度受限,从而导致其吸磷性能欠佳。
针对这一问题,团队选择具有大孔形貌的Q-CNF气凝胶为载体,提高了La(OH)3纳米棒在载体内部的负载量和分布均匀性,得到了负载纳米La(OH)3的Q-CNF杂化气凝胶(即L-Q气凝胶)。在大孔气凝胶和高负载量La(OH)3的协同作用下,L-Q气凝胶对磷酸盐最大吸附容量高达87.0 mg P g-1,吸附速率为粉末状纳米La(OH)3的3倍,其La的利用率也远优于纳米La(OH)3;经多次吸附-解吸附循环,该气凝胶吸附容量保持稳定,经简单碱洗即可再生;研究分析表明,吸附机理为配体交换和形成LaPO4沉淀。以上成果发表在Chemical Engineering Journal2022,433,134439(IF=13.273,JCR一区)上。论文的第一作者为王章慧讲师,通讯作者为刘宏治教授。

团队还以TEMPO氧化法制备的竹TO-NFC为骨架载体,选取3-氨基丙基三甲氧基硅烷为改性剂,制备了表面富含氨基的TO-NFC-Si-NH2气凝胶。研究发现,其对水体中重金属离子Cu2+,Cd2+及Hg2+显具有良好的吸附效果和再生性能。以上成果发表在International Journal of Biological Macromolecules2021, 190, 170(IF=6.953,JCR一区)上,论文通讯作者为刘宏治教授、浙江农林大学吴胜春教授和刘晓欢讲师。
“生物质高分子材料团队”现有骨干科研人员3人,其中省“重点人才计划”专家1名、副教授1人、讲师1人,以纤维素纳米纤维(CNF)和聚乳酸(PLA)高值化应用技术开发为目标,结合化学合成、材料改性及加工手段,围绕CNF高效低成本放大制备、CNF基功能性膜材料(包括抗菌阻氧、阻燃抗紫外、分离膜)、CNF增强热塑性树脂复材、PLA用新型生物基改性剂分子设计四个方向开展研究。